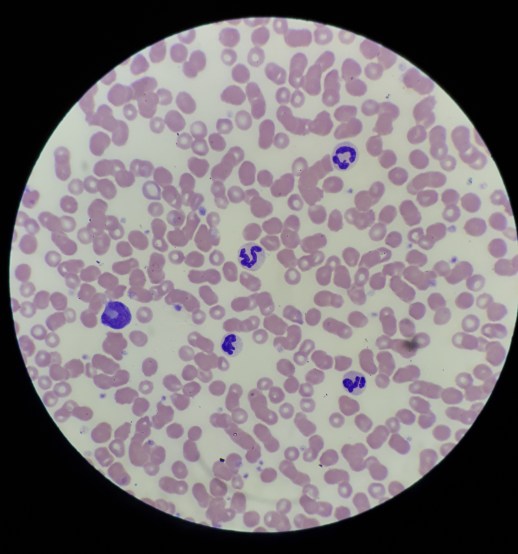
20180524_100712

The diagnostics rotation is very different from everything else we’ve done this year. We were back to sitting in chairs and focusing on one topic all day long–it was a difficult transition for some of us. This was not my favorite rotation, but it was very good to practice reading blood smears, blood results, x-rays, and performing post mortem exams. The rotation was split into three components: clinical pathology, radiology & imaging, and anatomic pathology.
Clinical Pathology
This rotation was mostly self directed learning. We had a variety of cases to work through ourselves. We had several hematology and biochemistry cases to look at (blood work) and cytology cases (slides of cells). We spent many hours looking down a microscope and compiling our answers all together. One morning we all gathered in the lab and practiced doing packed cell volumes (PCVs) and blood smears. We also practiced doing urinalysis and looking at the sediments for the cells under the microscope. The ‘sediment’ in a urine sample is all the cells and crystals and other things present in the urine; you can collect them on a microscope slide after you spin the sample in a centrifuge machine.
Blood under the microscope
Radiology & Imaging
The second component of our diagnostics rotation was radiology and imaging. We started with the musculoskeletal system, and then thorax and abdomen. We were given multiple x-ray films from cats, dogs, and horses. We had normal x-rays to look at as well. There were several radiology cases to work through and then we had to present a couple cases and our findings to the radiologist. When animals in the hospital needed a x-ray our group would go and assist with positioning the patient on the table and exposing the x-ray. We also looked at the images with the specialists in the radiology room. On the final day of the rotation we had a ‘positioning assessment’ where we had to position a stuffed dog model for different radiographic views.

My group in the CT room practicing the positioning of ‘Emily’ for her x-rays
I have always enjoyed ultrasounds, so I thought it was very cool when we got some hands on ultrasound practice during this rotation. The first time we got to practice was on the ‘phantom’ which is a specially made box with spheres and wires hidden inside gel that we used the probe to detect. The phantom helps us learn how to manipulate the settings on the ultrasound to better find an image. The next day we had a LIVE dog to practice on! We started by finding the kidney in a longitudinal plane and then moving the ultrasound probe to image it in a different view, then moving the probe around the abdomen to look at the spleen, liver, intestines, and bladder. We were supposed to have a 3rd day to practice with the ultrasound and a live patient, but there was no dog available to us. We ended up ultrasounding each other—I am happy to report that I have a gall bladder but possibly only 1 kidney (jk I probably have two kidneys but we couldn’t find the other one).
Anatomic Pathology
Post mortems can be completed on animals as a diagnostic test to help determine the cause of death–especially if it was unable to be determined while the animal was still alive. The first post mortem we did was a congo buffalo from the free range zoo. Before she died she was walking very weirdly; Her movements looked similar to a disease we see in horses called ‘Stringhalt’. She was immobilized with Etorphine prior to euthanasia. Etorphine is a drug that is very dangerous to humans and can be absorbed through skin and cause immediate cardiac arrest (depending on dose). Because of this we had to wear full PPE (personal protective equipment) and be briefed on what symptoms to watch out for in ourselves and our colleagues. We had someone on standby with a reversal drug. As well, we marked off the leg that the buffalo was darted in & removed that leg prior to starting our necropsy.

A Congo Buffalo! (No, I also had no idea what they looked like before we saw her)
The second post mortem we performed was a dog that had died due to a dog attack. It was very interesting to see the full extent of the damage from the bite wounds that were not visible externally. The damage likely wouldn’t have been able to be identified with any imaging modalities either. This experience will influence how I treat future trauma and dog attack cases because I am now better able to understand how many ‘hidden problems’ these patients have.
Our 3rd and most exciting post mortem was a whale! My group was very lucky to be involved in this post mortem. The whale was stranded in shallow water and was unable to be resuscitated. Our group and our pathology professors took a little field trip down to the zoo to perform the necropsy at their facilities. We wore full PPE again to protect ourselves against diseases that we might pick up from a marine mammal. Our team was organized—one person was in charge of measurements, ensuring all appropriate samples were collected & organized, others were in charge of examining different body systems. We discovered a massive gastric impaction with sea grass. When we opened one of the stomach compartments there was a large sheet of plastic as well. After doing some research for our post mortem report, we learned that this species of whale eats squid, not sea grass. We suspect that after eating the plastic she may been more inclined to eat an abnormal diet and started eating the sea grass because she had abdominal pain. Unfortunately, she was also pregnant.

Hanging out in our PPE suits!
My favourite part of this rotation was the post mortems, especially because we got to work with some very interesting species. However, I’m excited to move on to the next one and get more action in my day!

